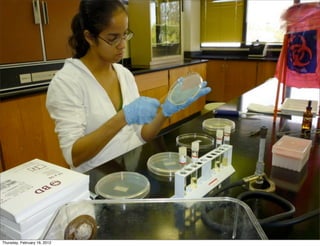
Thursday, February 16, 2012

This document outlines the presentation of the STEMmED program at Universidad del Sagrado Corazón. STEMmED aims to increase the number of Hispanic students in STEM fields through outreach programs, undergraduate research opportunities, lab renovations, faculty development, and curriculum redesign using web 2.0 technologies. The presentation discusses the program components and their objectives, as well as evaluation results showing increased student retention and positive feedback on use of web 2.0 in courses. Future plans include continuing and expanding the program over the next 5 years.